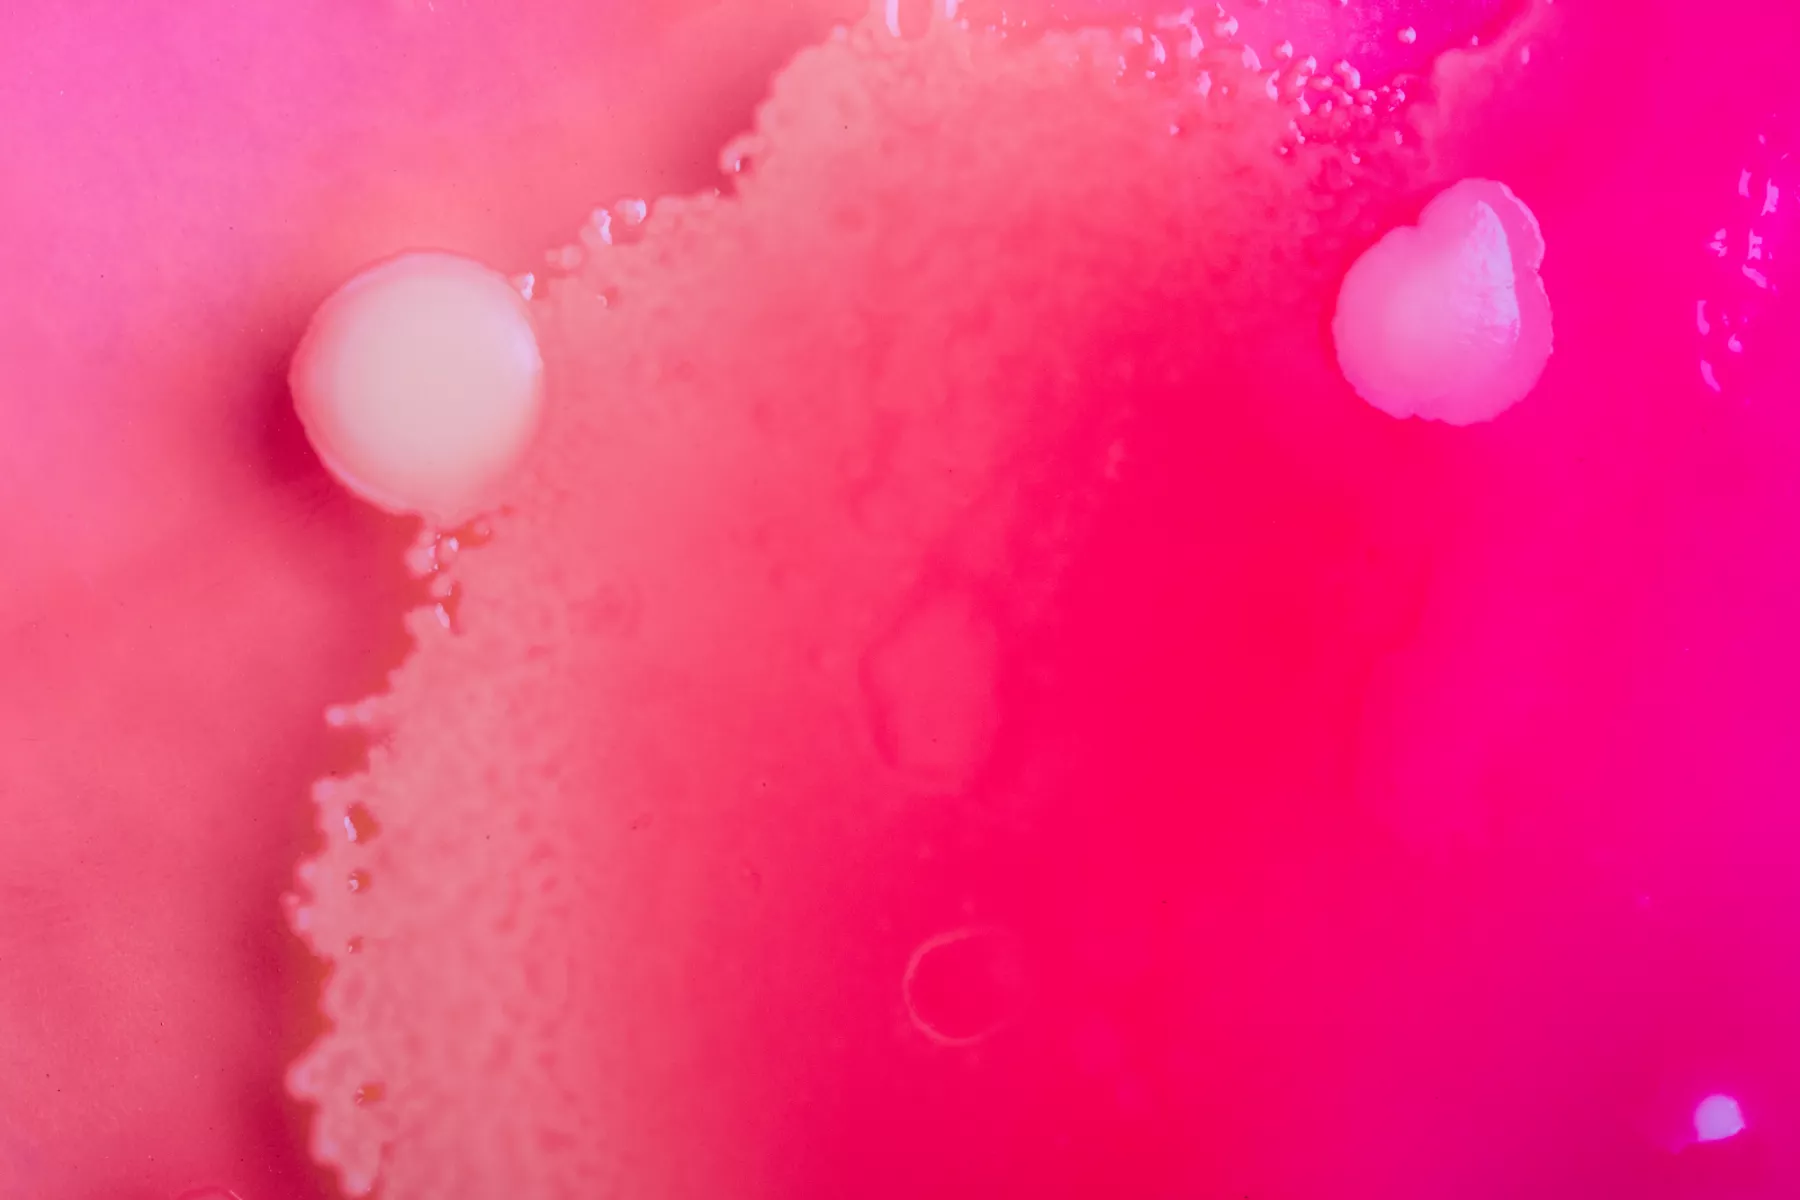

-
Technologies
Antimicrobial
Odor Capture
Coatings
-
Services
Services
Testing
-
Partnerships
Partnerships
Working with Microban
- Resource Center
-
About Us
About Us